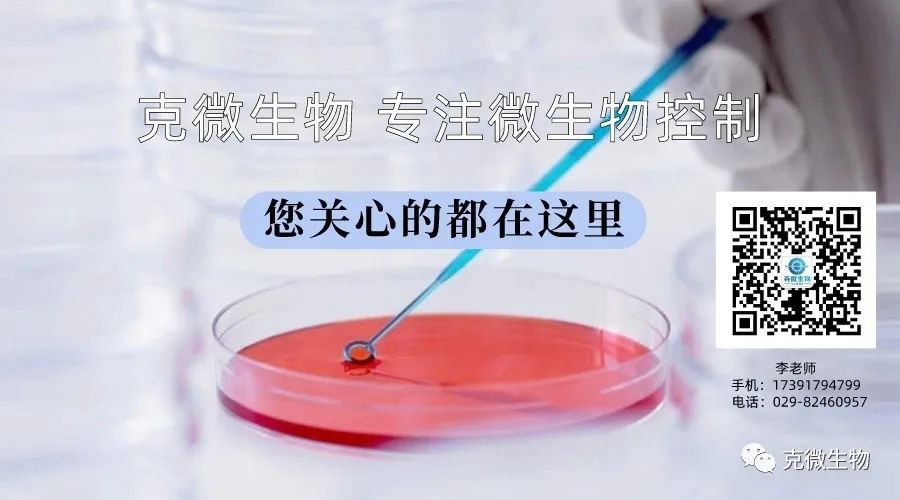

关键词:过氧化氢 过氧化物 过氧化氢酶 食品生产企业
01
—
过氧化氢酶在食品生产中的应用
过氧化氢酶是采用生物技术生产的液体酶,能有效的将过氧化氢(双氧水)分解为氧和水,其只对过氧化氢起作用,广泛应用于清除食品、食品配料和食品添加剂等在消毒灭菌、漂白,加工后产生或残留的过氧化氢。清除食品(如奶制品、蛋制品)在紫外线照射时产生的过氧化氢造成的特殊异味,避免人体过量摄入过氧化氢后发生中毒的危险。
然而,需要注意的是,在使用过氧化氢酶时,必须按照正确的方法和比例使用,以避免对食品产生负面影响。如果使用不当,过氧化氢酶可能会对食品的口感、营养价值和安全性产生不利影响,甚至会引起食品中毒等问题。因此,在使用过氧化氢酶时,食品企业必须严格遵守相关规定和标准,确保过氧化氢酶的使用安全可靠。同时,还需要对过氧化氢酶进行定期检测和评估,以确保其质量和效果,并及时调整使用方法和比例,以适应市场需求和食品生产的变化。

02
—
如何降低过氧化氢酶的使用量?
降低过氧化氢酶的使用量可以通过多种途径实现。选择适当的方法,不仅可以减少成本,还可以提高反应效率,达到更好的反应效果。
1. 使用优化的反应条件:优化反应条件可以提高催化效率,从而减少过氧化氢酶的使用量。例如,通过优化温度、pH值、底物浓度等反应条件,可以提高反应速率和选择性,从而减少过氧化氢酶的使用量。
2. 使用辅助催化剂:辅助催化剂可以协同过氧化氢酶,提高催化效率,并降低过氧化氢酶的使用量。例如,使用金属催化剂、离子液体、纳米材料等辅助催化剂,可以增加反应位点、提高选择性,并减少过氧化氢酶的使用量。
3. 使用再生过氧化氢酶:过氧化氢酶可以通过再生方法,降低使用量。例如,使用还原剂、洗涤剂、离子交换树脂等再生过氧化氢酶的方法,可以延长过氧化氢酶的使用寿命,并减少使用量。
4. 使用改良的过氧化氢酶:改良过氧化氢酶可以提高酶的催化效率和稳定性,并降低使用量。例如,使用蛋白工程、酶改造、基因编辑等技术改良过氧化氢酶,可以提高催化效率和选择性,降低使用量。
5. 使用替代催化剂:替代催化剂可以替代过氧化氢酶,降低使用量。例如,使用过氧化物酶、金属催化剂、酶模拟体等替代催化剂,可以提高催化效率和选择性,并减少使用量。总之,通过优化反应条件、使用辅助催化剂、再生过氧化氢酶、改良过氧化氢酶和使用替代催化剂等方法,可以降低过氧化氢酶的使用量,并提高催化效率和选择性。

03
—
诺福,食品行业的理想消毒剂
诺福是食品行业的理想消毒剂,食品级过氧化氢、无色无味无毒,能够杀灭霉菌、大肠杆菌、酵母菌等食品行业存在的微生物,还可以杀灭芽孢、孢子等高抗性微生物,使食品满足微生物控制标准,令食品拥有更长的保鲜期,符合国内和国际标准。
诺福单位使用量极低,可以大幅度降低食品生产中过氧化氢酶使用量,是目前最新一代的高效、广谱、安全的杀菌、保鲜剂,已在世界范围内被广泛的应用。挪威,英国,荷兰,比利时等大多数欧洲国家已经将诺福作为消毒、保鲜剂的首选,同时产品在澳大利亚、东南亚、非洲各地也被越来越多的食品类生产厂家接受。
产品特点:
1、诺福具有高效广谱的杀菌能力,能够全面杀灭细菌、真菌、病毒等所有类型微生物;
2、食品级,无色无味,无毒无残留,作用后分解为水和氧气;
3、使用后不会影响食品口味和外观;
4、单位用量极低,无腐蚀,与金属、塑胶、丝织物等各种材料兼容;
5、适用范围广,可用于墙壁、地板、空气、设备表面、器皿、水等各个环节的消毒灭菌工作,可通过喷雾、涂抹、擦拭、浸泡等各种方式工作;
6、具备国家消毒产品备案。

